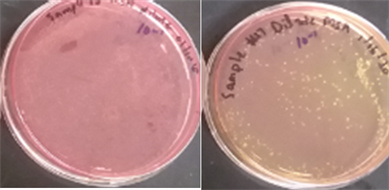

根據近日發表在《Advances in Infectious Diseases》期刊上的論文,指出大多數智能手錶用戶不會清理錶帶,因此積累了葡萄球菌和大腸桿菌等大量細菌。
來自佛羅里達大西洋大學的科研團隊測試了塑料,橡膠,布料,皮革和金屬等不同錶帶材質,發現 95% 的錶帶都存在危險細菌。





報告中指出,85% 的錶帶上存在引發葡萄球菌感染的葡萄球菌屬;60% 的錶帶上存在大腸桿菌;30% 的佩戴者在假單胞菌屬(Pseudomonas)測試中呈陽性,這是一種與膿毒症和肺炎有關的耐抗生素細菌。

測試結果顯示布料材質的錶帶存在細菌數量最多,然後是塑料和橡膠,其次是皮革;而由金或者銀製成的金屬錶帶,攜帶的細菌數量最少。
來源:IT之家
更多遊戲資訊請關註:電玩幫遊戲資訊專區
電玩幫圖文攻略 www.vgover.com


















